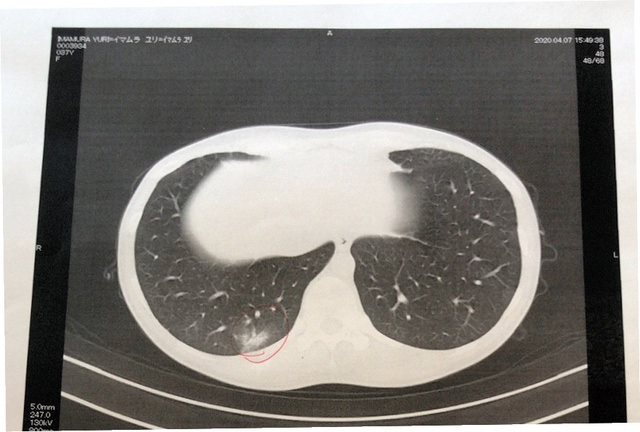

幼子2人抱え、夫には持病が 感染した記者の60日間
今村優莉
朝日新聞社は4月4日、東京本社に勤務する30代の女性記者が新型コロナウイルスに感染したと発表しました。記者として経験を伝えたいという今村記者の意思を踏まえ、署名記事として報道します。
また、今村記者から嗅覚(きゅうかく)・味覚障害の申し出を受けて過去2週間の行動や接触していた人を聞きとりました。接触した人には2週間の健康観察をするよう指示しました。期間中に健康の異常が確認された人はいませんでした。
幼子2人抱え、夫には持病が 感染した記者の60日間
幼子2人抱え、夫には持病が 感染した記者の60日間
記者(37)は3月末、新型コロナウイルスに感染しました。家族に感染させないよう苦心した隔離生活、入院、退院後も続く症状。今も大勢の命を奪うウイルスの恐ろしさを実感し、感染者のニュースに心が痛みます。国内全域で緊急事態宣言が解除されましたが、第2波への懸念は残ります。記者の感染経路も分かっていません。経験を伝えることで、少しでも感染拡大を防ぐことにつながって欲しいと願っています。
味覚に違和感、決定打はにおい
今思えば、最初の兆候は、1杯のホットコーヒーだった。首都圏で初めて、週末の外出自粛要請が出た3月28日。朝日新聞東京本社に出勤した私(37)はいつも通りにいれたコーヒーを、お湯っぽいと感じた。同じものを飲んでいた女性は「おいしい」と言う。ただ、この時はまだ、自分の味覚の異変に気づかなかった。
国際報道部に所属する私は、中国・武漢市で新型コロナの感染が爆発的に拡大した1月下旬以降、電話やSNSを通じて感染者やその家族に取材を続けていた。その経験もあり、このウイルスがいかに感染しやすく、重症化すると怖いのかを痛感していた。2月下旬以降は対面取材を一切せず、週2回程度の出社当番を除き、可能な限り自宅で勤務していた。多人数での会食は延期かキャンセルし、外出の際はマスクをつけ、手は荒れるほど洗っていた。
体に異変が起きていると確信をしたのは、コーヒーを飲んだ約2時間後。エッセンシャルオイルを手指に塗った時だった。ラベンダーの香りがするはずなのに、どんなに鼻に近づけても何も感じない。消毒スプレーや除菌ティッシュも試したが、思いきり吸い込んでも、かぎ慣れたアルコール臭が分からない。
この時、都内の累計感染者数は約360人だったが、身の回りにはいなかった。私は熱やせきがなく、体調はむしろ良かった。しかし、直前には「においがしない」と訴えたプロ野球の選手が新型コロナに感染していたというニュースもあった。
医師「感染の疑いは限りなくない」
私から「においがしない」と一報を受けた夫(49)は長男(3)、次男(1)と自宅にいた。ホテルに泊まることや、どちらかが実家に身を寄せることも検討したが、陽性だったらかえって周りに迷惑をかけてしまう。
帰宅途中、開いている内科があった。入っても良いものか、表で逡巡(しゅんじゅん)していると、中から「大丈夫ですか」と話しながら女性が出てきた。
「熱はないのですが、においと味が分かりません」とマスク越しに伝えると、女性は一歩後ろに下がった。体温計を渡され、36度台であることを確認すると、受診の許可が出た。
診察した医師の意見は「嗅覚(きゅうかく)と味覚がないだけでは、コロナの疑いは限りなくない」だった。念のため、PCR検査を受けられないか質問したが、「熱がないんじゃ、受けられる見込みは100%ない。検査は、陰性を確かめるものではないからね」との答えだった。

地元の保健所にかけ続けていた携帯電話のリダイヤル記録。100回を超えることもあった
それでも不安で、自宅に帰ってから東京都の新型コロナ患者相談センターに電話をかけた。リダイヤルが200回を記録してようやくつながった担当者も、症状を聞くと「感染の疑いはないでしょう」と話した。「知らぬ間に、まわりに感染させていないか不安だ」と伝えると、「花粉症でもにおいがわからなくなることはある」「子育てで疲れているだけでは」と言われ、逆に安心すらした。
ただ、念のため家族とは別室で寝ることにした。上司からは2週間の自宅待機を伝えられ、過去2週間に社内外で行った場所や、接触した人についても、詳細な報告を求められた。
夫も職場に「妻がコロナ感染の疑いがある」と伝えると、当面在宅勤務になった。保育園と相談し、子どもたちを預けることも見合わせた。夫が在宅勤務をしながら、幼児2人と、感染疑いが晴れない妻の世話をするという、想像したこともない生活が始まった。
病院3カ所に受診を断られ
31日になって、倦怠(けんたい)感とだるさが始まった。熱は37度程度で、せきはない。でも、立ちあがるのもつらく、力が入らない感じだった。明らかに2日前よりも体が重い。

普段は取材に使うノートに、自分に何が起きていたかを記した。発症当日から退院まで、1日も欠かさずに書き続けた
さらに、少し息切れをしているのに気づいた。深呼吸するとせき込みそうだったから、意識して浅く息をするようにした。
再び不安になり、保健所に電話すると、担当者から「まずはかかりつけ医を受診してみて下さい」と言われた。
かかりつけ医には、設備がないため受診は難しいと断られたが、代わりに呼吸器科のある病院の紹介状を書いてくれた。自家用車を自分で運転して向かうと、男性の事務員が駐車場の近くで対応し「院長は感染の疑いがあると言っているので、保健所にそう伝えてください」と言われた。診察もされていないのに、いいのだろうかと思ったが、念を押すと「院長がそういうので」との返事だった。
近くの総合病院にも電話し、症状を伝えたが「受診はできません」「保健所に連絡して」と言う。その保健所に「病院で診てもらって」と指示されているのに。どうすればいいのか、途方にくれた。
車で移動しながら、空いているコンビニの駐車場をはしごし、車内から保健所に電話をかけ続けた。134回目でつながった担当者に「三つの病院で診察を断られ、その一つから、『感染の疑いがあるから、PCRを受けて』と言われました」と伝えると、「検査を検討します」と返事してもらえた。
翌4月1日の昼ごろ、保健所から電話があり、「夕方にPCR検査を受けられる」と案内された。「公共交通機関は使わないように」とも注意された。高齢者や車を持っていない人はどうすれば良いのだろうと思いながら、車のハンドルを握った。
指定の病院へ行くと、検査は夜間救急外来の近くに設置された白いテント内で行われていた。青い防護服をまとい、フェースマスクを着けた医師が簡単な問診をした後、長い綿棒を左の鼻孔にグイと差し込み、終了。保険証を確認するといった手続きも一切なく、滞在時間は4分足らずだった。

PCR検査を受けた医療機関に設けられていた、検査のテント=2020年4月1日午後、東京都内
検査結果が出るまで、短くても3日かかるという。その間の注意事項として「自宅で過ごすこと/家族と部屋を分け、食事や寝室も別にする/タオルや食器の共有を避ける」などと書かれたA4の紙を渡された。帰宅した私は玄関先で衣類を脱いで洗濯機に入れ、すぐにシャワーを浴びた。
寝るとき以外家でもマスク
「陽性である可能性」を意識し、自宅での隔離生活が本格化した。夫にはせきぜんそくの持病があり、長男は気管支が弱い。とにかく感染させてはいけない。普段は仕事に使っている小さな部屋に布団を持ち込み、こもり始めた。
トイレやシャワーなどのために部屋を出る際は、右手に消毒スプレー、左手にタオルを持ち、自分が触ったところを拭きながら移動した。ドアノブ、冷蔵庫のドア、水栓、便座、トイレの洗浄ボタン、照明スイッチ。シャワーは最後に入り、自分がその日使ったタオルや衣類は単独で洗濯機にかけた。どんなに気温が低い日でも、家中の窓を開け、換気した。

自宅隔離をしていたときに使っていた消毒液とタオル。自分が触ったあらゆるものを拭きながら移動した
食事は夫に部屋に運んでもらったり、子どもが寝ている隙に、食卓でとったりした。飛沫が飛ばないよう、無言のまま、短時間ですませた。使い終わった食器は家族と別のスポンジで洗い、専用の場所に。座った椅子とテーブルはその都度、消毒液でふいた。寝るとき以外、私も夫もマスクをつけ、1メートル以上離れて会話した。
「隔離」の意味が分からぬ子ども
ただ、3月に3歳の誕生日を迎えたばかりの長男と、1歳の次男には、状況を説明しても理解してもらえない。
私がこもった部屋に鍵はなかった。子どもたちは訳の分からないまま、突然姿を見せなくなった私を、朝から晩まで「ママ」と泣き叫んでさがした。トイレに行こうと、そろりと出ると「みつけた!」と言わんばかりに抱きついてくる。夫が駆けつけ、力ずくで押さえる。その繰り返しだった。
次男は、ママが抱っこしてくれなくなり、つんざくような泣き声を上げ続けた。長男は、両親が怖い顔をしながら、自分たちを母親から引き離すことの意味を、必死に理解しようとし、おびえた顔になっていた。
トイレから出ると、子どもから逃げるようにして部屋に駆け込んだ。「開けて」と部屋に入ろうとする子どもたちに「ごめんね、ごめんね」と叫びながら、内側からドアを押さえた。次男は、自分の指をわざとドアに挟みこみ、私がドアを閉められないようにした。その小さな指を「うつっちゃうから来ちゃダメ」と言いながら、ひじを使って押し戻した。
「ママは病気なんだよ」と夫が説明すると、長男はドア越しに「ママ、キスしていいよ」と繰り返した。ユーチューブで見た、風邪をひいた子どもにキスをする母親の動画を覚えていたのだ。
「伝染病にかかる」とはこういうことなのだと思い知った。目の前で母親を求める我が子に、キスはおろか触れることすらできない。ドアの向こうで叫び続ける子どもの声を聞きながら、「ごめんね」と繰り返し、カラーボックスでドアを塞いだ。
どうしてこんなことになったのだろう。自問自答を繰り返した。
あの日、電車に乗らなければ。
あの日、スーパーに行かなければ。
「まだ陽性か決まったわけではないじゃない」「子どもはとっくに濃厚接触している」との考えが何度も頭をよぎり、ドアを開けてしまいたい衝動にかられた。「同じ苦しみを家族に与えるのか」という理性で、必死におさえ込んだ。
全身を刺すような痛み
PCR検査を受けた翌日から、全身の痛みが始まった。体の内側から無数の針が筋肉を刺しているようだった。横になっても座っても、体重がかかる部分に針が沈み込むような激痛が走り、立ってじっとしているしかない。夜も昼もまともに眠れなかった。頭痛に続き、下痢も始まった。それでも、熱とせきは出なかった。

発症当日から退院まで、1日も欠かさずつけていたノート。発症した3月28日には、電話の相談窓口から言われた言葉として「コロナの感染疑い段階とは言えず」とある
東京都で1日の感染者数が初めて3ケタになった4月4日、保健所からの電話で「体内にウイルスがいることが確認されました」と伝えられた。陽性という覚悟はしていたが、次の言葉に頭を抱えた。「病院はどこもベッドがいっぱいです。空いている場所を探していますが、入院のご案内はいつになるかわかりません。とりあえず今すぐご家族と離れて生活してください」。
家の中でどんなに離れようとしても、私が歩いたところを子どもは歩き、おもちゃの車を走らせ、それをなめる。「家の中では限界です。医療設備がなくても構いません。どこかに隔離してもらえませんか」「夫に感染したら子どもたちの面倒みる人がいなくなってしまう」と訴えた。電話の向こうの担当者は「お子さんがいることは最大限配慮します。もう少しこらえて下さい」と答えてくれた。
当面は自宅で過ごすしかない。武漢への電話取材で何度も聞いた、「感染者を自宅隔離することによる家庭内感染」の現実が、自分に降りかかっているのを感じた。
孤独というより恐怖 「ひと目会いたい」と母は泣いた
孤独というより恐怖 「ひと目会いたい」と母は泣いた
PCR検査の結果が陽性と判明し、新型コロナウイルスへの感染が確定したのは4月4日午後。呼吸器の持病がある夫(49)と、感染症の怖さが理解できない長男(3)、次男(1)がいる自宅マンションでの隔離生活は、すでに限界に近かった。
この前日には、東京都の小池百合子知事が、病院の負担を軽減させるため、軽症者らをホテルなどの宿泊施設に移動させる方針を発表していた。私(37)は検査結果を伝えてくれた保健所の担当者に、こうしたホテルに入れないか聞いたが、「こちらもテレビを見て知っている程度です。現場にそんな話はまったくおりてきていません」との返答だった。
「何が一番大変ですか」と聞いた担当者に「小さな子どもが2人いる。高齢の両親にも頼れない」と伝えると「配慮します」と言ってくれた。
70代の義母は、私が陽性診断を受け、「自分も近々発症するかもしれない」と夫に言われると「その時は私が(子供を)預かる」と答えたという。義父とも相談し、2人で孫を受け入れる覚悟を決めた。だが、症状がなくても、子どもたちも感染している可能性はある。高齢者として重症化するリスクの高い義父母に預ければ、命とりにもなりかねない。
どうすればいいのか、答えが見つからないまま、6日の夕方、保健所から電話がかかってきた。入院先が見つかったという。「今から約30分後に車で迎えに行きます。マスクをして家の前でお待ち下さい」。家族に感染させるリスクが減ることに、心からホッとした。夫も安心した様子で「ママ、病気を治しに行くんだよ」と子どもたちに説明していた。発症して10日目のことだった。
1日4回の体温測定が「治療」
洗面用具や数日分の着替えなどをカバンに詰め、迎えを待った。全国の累計感染者数は約4800人を記録し、テレビでは安倍晋三首相が緊急事態宣言を出すと表明していた。
自宅のあるマンションの前まで迎えにきたのは「民間患者等搬送車」と書かれたワゴン車だった。ビニールで仕切られた助手席には保健所の担当者も同乗していた。車は私を乗せたあと、近くで別の女性患者をピックアップし、入院先の夜間救急外来の入り口で止まった。防護服を着た医療スタッフに導かれエレベーターに乗り、病室のあるフロアに着くと、事件現場で見る「立ち入り禁止」の黄色いテープが張られていた。視界に入るすべての人が防護服を着ており、至るところに消毒液やビニール手袋が置かれていた。
翌日受けたCT検査で、私は軽い肺炎症状が確認されたが、医師は「自然に治るレベル」と話し、特に薬は出なかった。1日4回の検温と、血圧と血中酸素濃度の測定が、毎日の「治療」だった。医師は「この病気に特効薬はありません。しっかり食べて安静にして、体力と免疫をつけてウイルスをやっつけましょう」と語った。
私が入ったのは、軽症者を集めた4人部屋。トイレは室内にあり、部屋から唯一出られるのは、廊下にある男女共用のシャワーに行く30分だけ。院内の売店に行くことはできず、欲しいものがあれば看護師に注文用紙を渡す仕組みだった。当然、家族を含めて面会はできない。1日の会話は、診察のために訪れる看護師とのやりとりがほとんどで、その看護師も防護服とマスクと防護ゴーグルで目以外は覆われているため、顔はほとんど分からなかった。

入院した翌日にCT検査を受けた私の肺の画像。赤いボールペンで囲んである部分が右の肺の炎症で、医師は「軽症のなかでも軽症です」と話した
スマホで見る子どもの動画が楽しみ
緊張が絶えない家庭内隔離から解放された安堵(あんど)はあったが、今度は家族の状況が分からなくなってしまった。病室の中で携帯電話やパソコンは使えたが、通話は禁止。廊下には通話エリアがあるが、そこで話すために室内から出ることは許されなかった。
夫は子どもたちの動画をLINEで送ってくれた。小さな画面越しに子どもの元気な様子を見ることが、一番の癒やしだった。しかし、返事は文字でしか送れない。スマホのテレビ電話機能を使って、向こうの声だけイヤホンで聴いた。私は声を出せないため、精いっぱいの笑顔を画面に送った。

最初に入院した病室のベッド=2020年4月6日
「ママ、痛いの?」。病院にいることを理解したらしい長男に「痛くないよ」と伝えようと、頭をぶんぶん振ってみせた。長男は「ママの声、聞こえないよ」。夫に「元気だと伝えて」と文字で送る。不思議そうな顔を画面いっぱいに近づける子どもに、直接語りかけてあげられないのがもどかしかった。
保健所は、私が入院した後も子どもや夫に感染の兆候がないか、定期的に夫に連絡をして確認してくれていたという。発症当日の朝まで一緒に過ごしていた家族は明らかに濃厚接触者だが、健康状態に異常はなかった。ただ、子どもたちは私がいなくなったあと、深夜に突然「ママは?」と起きたり、日中に理由もなく泣き出したりしていたという。
味が分からないご飯 それでも
食事は、味覚も嗅覚(きゅうかく)も失った私にとって楽しみとはならなかった。出し巻き卵と高野豆腐の含め煮の違いもわからないのに、完食するのは苦行だった。それでも、体力をつけないといけない。私は味覚を失ったあとも、なぜか酸味だけは分かった。そのため夫に梅干しを送ってもらってご飯と一緒に食べ、マカロニサラダやさわらの照り焼きにしそ味のふりかけをかけて口に詰め込んだ。入院から3日たって、急にみそ汁の味が分かるようになった。冷めたみそ汁をあんなにおいしいと思ったのは、初めてだった。
重い症状はなかったが、37度前後の微熱が続き、頭痛や全身の痛みもひかなかった。ぐっすりと眠ることが出来ず、痛み止めの薬をもらってようやく眠りについた日もあった。

病院での食事はすべて、使い捨ての容器に入れられていた
症状落ち着きホテルへ移動
数日たち、東京都が軽症者・無症状者のための宿泊療養施設として用意したホテルが機能するようになった。
入院4日目の昼、私もホテルに移るよう言われた。味覚と嗅覚の障害と、微熱が続いていたが、他に症状はなく、医師から「満床なので1日でも早く入院を必要とする患者さんのために譲って頂きたい」と説明をうけた。
「自身の持ち物が、病院の壁やドアに触れないように移動してください」と注意されながら、私を含む6人の男女は、車内をビニールで覆われたワゴン車2台で移動した。
ホテルに到着すると、ロビーには防護服をまとったスタッフがおり、「ゆっくりお過ごし下さい」と言ってくれた。1日に3度、決められた時間にロビーでお弁当を受け取る以外は、部屋の外には出られない。それでも個室であることで、久しぶりに声を出して家族とテレビ電話を楽しむことができた。シャワーも、好きな時間にゆっくりと浴びられた。

軽症者・無症状者向けの療養施設となったホテルの部屋。いったんここに移動したが、同じ日のうちに病院へ戻されてしまった=2020年4月9日
病院と違って差し入れを受け取ることは認められず、洗濯のサービスもない。でも、それはささいなことだった。ここまで来たからには、家に帰れる一歩手前なのだ。お弁当を取りに行ったときにすれ違った患者はみな、動きや足取りが軽く、顔色もどことなく良く見えた。
ところが、到着した日の夜に悪寒がした。体温を測ると37度だが、部屋のエアコンの温度を上げても悪寒が止まらず、息をすると胸が痛んだ。私が滞在したホテルでは、何かあると内線電話で「事務局」につなぎ、そこから医療従事者に連絡をとってもらうことになっていた。事務局の人に症状を伝え、「寒いので毛布が欲しい」とお願いした。寝れば治る、と思っていた。
折り返しの内線が鳴った。電話の向こうは医師。「ここは基本的に軽症者か無症状の方が対象です。万が一に備え、病院へ戻ってもらえますか」
「え、ただ悪寒がするだけなのですが」。そういう私に医師は「急に重症になる方の中には、直前に悪寒を感じるなど、体調を崩す人もいます。何かあったときにここでは対応が間に合いません」
毛布を頼んだつもりが、病院に送り返されることになってしまった。ロビーに下りると、昼間に迎えてくれたスタッフが少し緊張した様子で「お気をつけて」と送り出してくれた。
病院へ戻るワゴン車を運転する防護服姿の男性は、普段は介護サービスの送迎をしているが、仕事が減ってしまったと話した。家には小さな子どもがいるため、家族から「リスクがある感染者の搬送はやめて」といわれているが、「普通の救急車が足りず、感染者を運ぶのをいやがる民間事業者もある」と説明してくれた。
夕方から雨が降り出し、気温も下がっていた。車内は凍えるほどだったが、「申し訳ないけど窓は開けたままでも良いですか」と聞く男性に「寒いので閉めてください」とは言えなかった。時折、窓から入ってくる細かい雨のしぶきを顔に浴びながら、初めて、このまま治らなければ、一生家族と会えないことに気づいた。
軽症だった私は、感染してからも死を意識したことはなかった。だが、良くならない限り、近しい人に直接声を聞かせることも、ふれ合うことも出来ない。それは、孤独というより恐怖に近かった。夫から再入院の知らせを聞かされた母親は「できるなら代わってあげたい。その前に一目会いたい」と電話口で泣いていたという。
病院に戻ると、体温は38度になっていた。(今村優莉)
退院から5週間 今もオムツのにおいがわからない
<振り出しに戻った。軽い症状なのに。つらい>
新型コロナウイルスの症状が最初に出た日から2週間目、4月10日につけた日記の一文だ。一度は病院から軽症者向けの療養施設のホテルに移った私(37)は、半日もたたないうちに医師に「症状が悪化する恐れがある」と判断され、再び病院に戻ってしまった。
今回も4人部屋だが、前回とは部屋が違った。前はベッドが窓側で、昼間には外の景色も見えたが、今回はそれもない。楽しみがなくなり、気分も少し落ち込んだ。
それまでなかった熱もじわりと出始め、37〜38度をうろうろとする日が続いた。ただ、高熱ではないこともあり、医師からは「この熱は体がウイルスをやっつけるために必要なので、解熱剤を出していません」と言われた。一度は治まった倦怠(けんたい)感も復活し、スマホを見たり、起き上がって食事をとったりするのもつらかった。一方で、病院食のおかずの味が少しずつ分かるようになるなど、緩和されていく症状もあった。
同じ部屋の患者もみな「軽症者」だが、症状や度合いはさまざまだった。カーテンを閉めていることが多く、入れ替わりもあったので、ゆっくり会話することは少なかったが、次第に互いの状況を知った。
2回連続で陰性が出れば退院できるが
救急車で横になったまま運ばれてきた女性(45)は、飲食店の経営者。懇親会に出席したところ、知人数人とともに感染してしまったと話した。激しいせきを繰り返し、夜中も「苦しい」と言ってナースコールを鳴らした。入院してから3日間、1日で36度と38度をいったり来たりする日が続いたのがつらかったと振り返った。
隣のベッドの女性は、カーテンを閉めっぱなしだった。時折、看護師に「ごはんが食べられない」とつらそうに話す声が聞こえた。人工呼吸器をつけたまま、食事がとれずに点滴を打っている人もいた。夜中に運ばれてきた高齢者の女性は、自分が病院にいる理由が分からない様子で、「家に夫がいる。発熱していて体調が悪い」と訴えていた。
別の部屋からは赤ちゃんの泣き声が聞こえてきた。看護師に聞くと、母親と一緒に入院しているらしい。家庭内感染をしてしまったのだろうか。泣き声が聞こえるたび、無事に治って欲しいと願い、自宅にいる自分の息子たちのことが気になった。
入院患者は、熱が37・5度以下で症状がない状態が2日続けば、PCRの再検査を受けられる。さらに規定の時間をあけ、2回連続で陰性が出れば退院できる。
再入院して5日目、私は最初の条件を満たしたとしてPCR再検査を受けた。翌日に陰性が確認され、医師は「良かったですね」と言葉をかけてくれた。これまでの苦労が報われたと思い、跳び上がって喜ぶキャラクターのアイコンをつけて、夫や両親にメッセージを送った。「次も陰性が出たら、その日のうちに退院できるよ!」
ただ、このころは38度近い熱が出てはひき、体調は万全とは言えなかった。それでも私は「熱があっても、検査で陰性がでれば退院はできるだろう」と自分に言い聞かせ、荷物をまとめていた。1回目の検査の2日後には、2回目の検査も受けた。

病室のドアには「許可された場合以外部屋を出ないでください」と貼り紙がされていた
予期しなかった「偽陰性」
2回目の検査の結果を待っていると、医師が残念そうな顔で病室に入ってきた。
「1回目の結果は『偽陰性』の可能性があるため、無効と判断しました」
一瞬、何の話をされているのか、のみ込めなかった。説明によると、私の症状からして、再検査で出た陰性は「検査の精度や環境によってたまたま出た陰性であり、ウイルスが体から抜け切ったという状態とは言い難い」という。ギインセイ。テレビで聞いたことはある言葉だったが、自分に起こるとは想像もしなかった。
「退院できると楽しみにしていたのに、残念ですね」。防護ゴーグル越しに言ってくれた医師の言葉に、私は心を読まれたようで思わず両手で顔を覆った。医師は気遣ってくれ「短時間なら良いですよ」と、廊下の通話エリアに出て家族と直接連絡をとることを認めてくれた。

4月15日、医師から「偽陰性の可能性があります」と告げられた日の日記。「自分の身に起きるとは考えもしなかった」とも書いてある
院内から携帯電話をかけたのは初めてだった。「偽物の陰性なんだって」。夫に伝えると「そうなんだ。でも、熱出ていたし、ちゃんと治るまでは病院にいた方がいいよ」と言ってくれた。
テレビでは、世界の感染者が200万人を突破した、と流れていた。韓国では一度陰性になって退院したのに再び陽性になった人がいる、とキャスターが深刻な顔で伝えていた。
チャンネルを変えたが、新型コロナに関連しない番組はなかった。見るのがつらくなり、入院以来、必ずつけていたテレビをこの日から消した。ツイッターもフェイスブックも、ニュースサイトもしばらく見るのをやめ、イヤホンで耳をふさぎ、音楽を聴きつづけた。
「偽陰性」から2日間、ひたすら安静に過ごした。17日に再度臨んだPCR検査で陰性が確認され、20日に2回目の検査。その日のうちに陰性が確認された。熱もひいており、退院の許可が出た。最初の入院から15日目、発症から24日目だった。
私が2回目の陰性を伝えられたのと同時に、同室だった女性(60)は陽性と伝えられた。1回目が陰性で、体調もとても良さそうだっただけに、ひどく落ち込んでいた。「先に退院できてうらやましいです」と声をかけてくれたことを機に、私たちは互いの話をした。女性は、持病があるために外出は極力控え、細心の注意を払っていたのに感染したことなどを話してくれた。私は、ホテルから再入院したことや、偽陰性の経験を伝えた。女性は「本当にやっかいな病気なんだね。でも、諦めずに頑張るしかないよね」と語った。
病室から出て、ナースステーションの前を通るとき、私に「偽陰性」を伝えてくれた医師と目があい、「お世話になりました」と頭を下げた。「今村さん、ご退院です」と隣にいた防護服姿の女性が少し大きな声で言うと、その場にいた医師と看護師が私の方を向き、「おつかれさま!」「よく頑張りました」と拍手をして見送ってくれた。過酷な状況で激務をこなし、私たちの命を守ってくれた医療者たちへの感謝の気持ちでいっぱいになり、私は再び頭を下げた。

日々の病院食についてくる、食事のメニューが書かれた紙。食べながら、味がわかるかどうかを○や×で記録した
退院後も残る嗅覚(きゅうかく)の異常
病院の玄関の外まで夫と2人の息子が車で迎えに来た。お互いマスクはしていたが、夫は「おかえり」とハグしてくれ、3歳の長男は「ママ!」と飛びついてきた。1歳の次男は、しばらくぽかんとしていたが、少しすると私の太ももに絡みついたまま、片時も離れなくなった。家に着いたあとも、私の姿が少しでも視界から消えるとパニックになったように泣き叫んだ。この3週間あまり、不安にさせていたことを心でわび「ママ、もう大丈夫だよ」と抱きしめた。子どもたちを抱っこしてあげられるって、こんなに幸せなことだったんだ。日常のありがたみをかみしめた。
発症した時、約360人だった都内の感染者数は3千人を超えていた。だが、私が入院してから自宅で経過観察をするよう保健所に指示されていた、家族の健康に異常はなかった。
保健所に退院の報告をすると、担当者は「ご家族にうつらなくて本当に良かったです。お父さんもお母さんも、よく頑張りましたね」とねぎらってくれ、「外出の際はマスクをつけたうえで普通の生活にもどっても良い」という許可が出た。夫は5月中旬、民間の医療機関で自費で抗体検査を受け、陰性が確認された。自宅隔離がうまくいったことが裏付けられたようでホッとした。同じ医療機関で抗体検査を受けた私は陽性だった。
私は退院してから1週間は、頭痛とだるさが交互に続いたが、コーヒーの味は分かるようになってきた。最初は微糖の甘さを感じ、次にブラックの苦さも分かった。2週間たつと、頭痛はおさまり、エッセンシャルオイルの香りも分かるようになった。元の体に戻ってきている実感があった。
だが、退院から5週間がすぎても、分からないにおいがある。子どものウンチだ。次男が泣いている意味がわからず、オムツからはみ出た排泄(はいせつ)物を見た時、「このにおいが分からない私は、本当に陰性なのか」と、背筋が凍った。気づいてあげられなかったことに、親としてもショックだった。新型コロナウイルスとの闘いは、まだしばらく続くのだろう。
全世界で620万人以上が感染し、37万を超える命を奪った新型コロナウイルス。私は医師や看護師、保健所や家族、友人らの支えで回復できた。だけど、感染の数だけ、さまざまな症状で苦しむ人がおり、罹患(りかん)していない人たちも大きな不安を抱いている。この不安から逃れられる日は来るのだろうか。安心して生活できる社会に戻ることを、心から願う。(今村優莉)